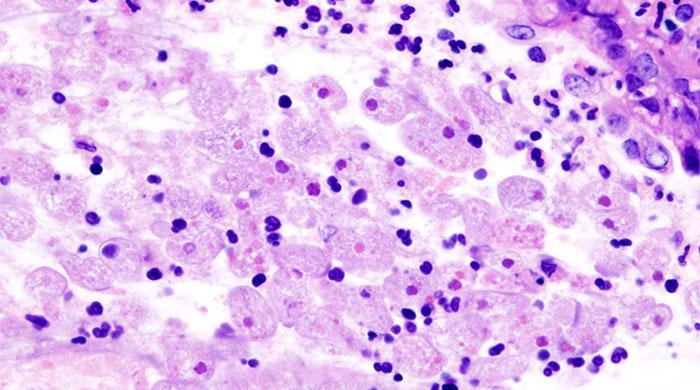
Naegleria claims year’s first victim in Karachi

Naegleria claims year’s first victim in Karachi
The victim, identified as 30-year-old Zahid Khan, was admitted to a private hospital in critical condition three days ago
July 01, 2016
KARACHI: Naegleria fowleri, the ‘brain-eating amoeba’, claimed its first victim in the port city on Friday, Health Department sources said.
Suffering from high fever, the victim, identified as 30-year-old Baldia Town resident Zahid Khan, was admitted to a private hospital in critical condition three days ago, sources said.
Naegleria fowleri, the brain-eating amoeba found in freshwater, claimed 14 lives in Sindh in 2015, most of whom were residents of Karachi.
Doctors and health experts say Naegleria usually enters the brain and attacks the nervous system when infected water is ingested through the nasal cavity while bathing, swimming or making ablution.
The lethal amoeba survives on bacteria in warm waters and can only be decimated through proper chlorination or boiling of water.









